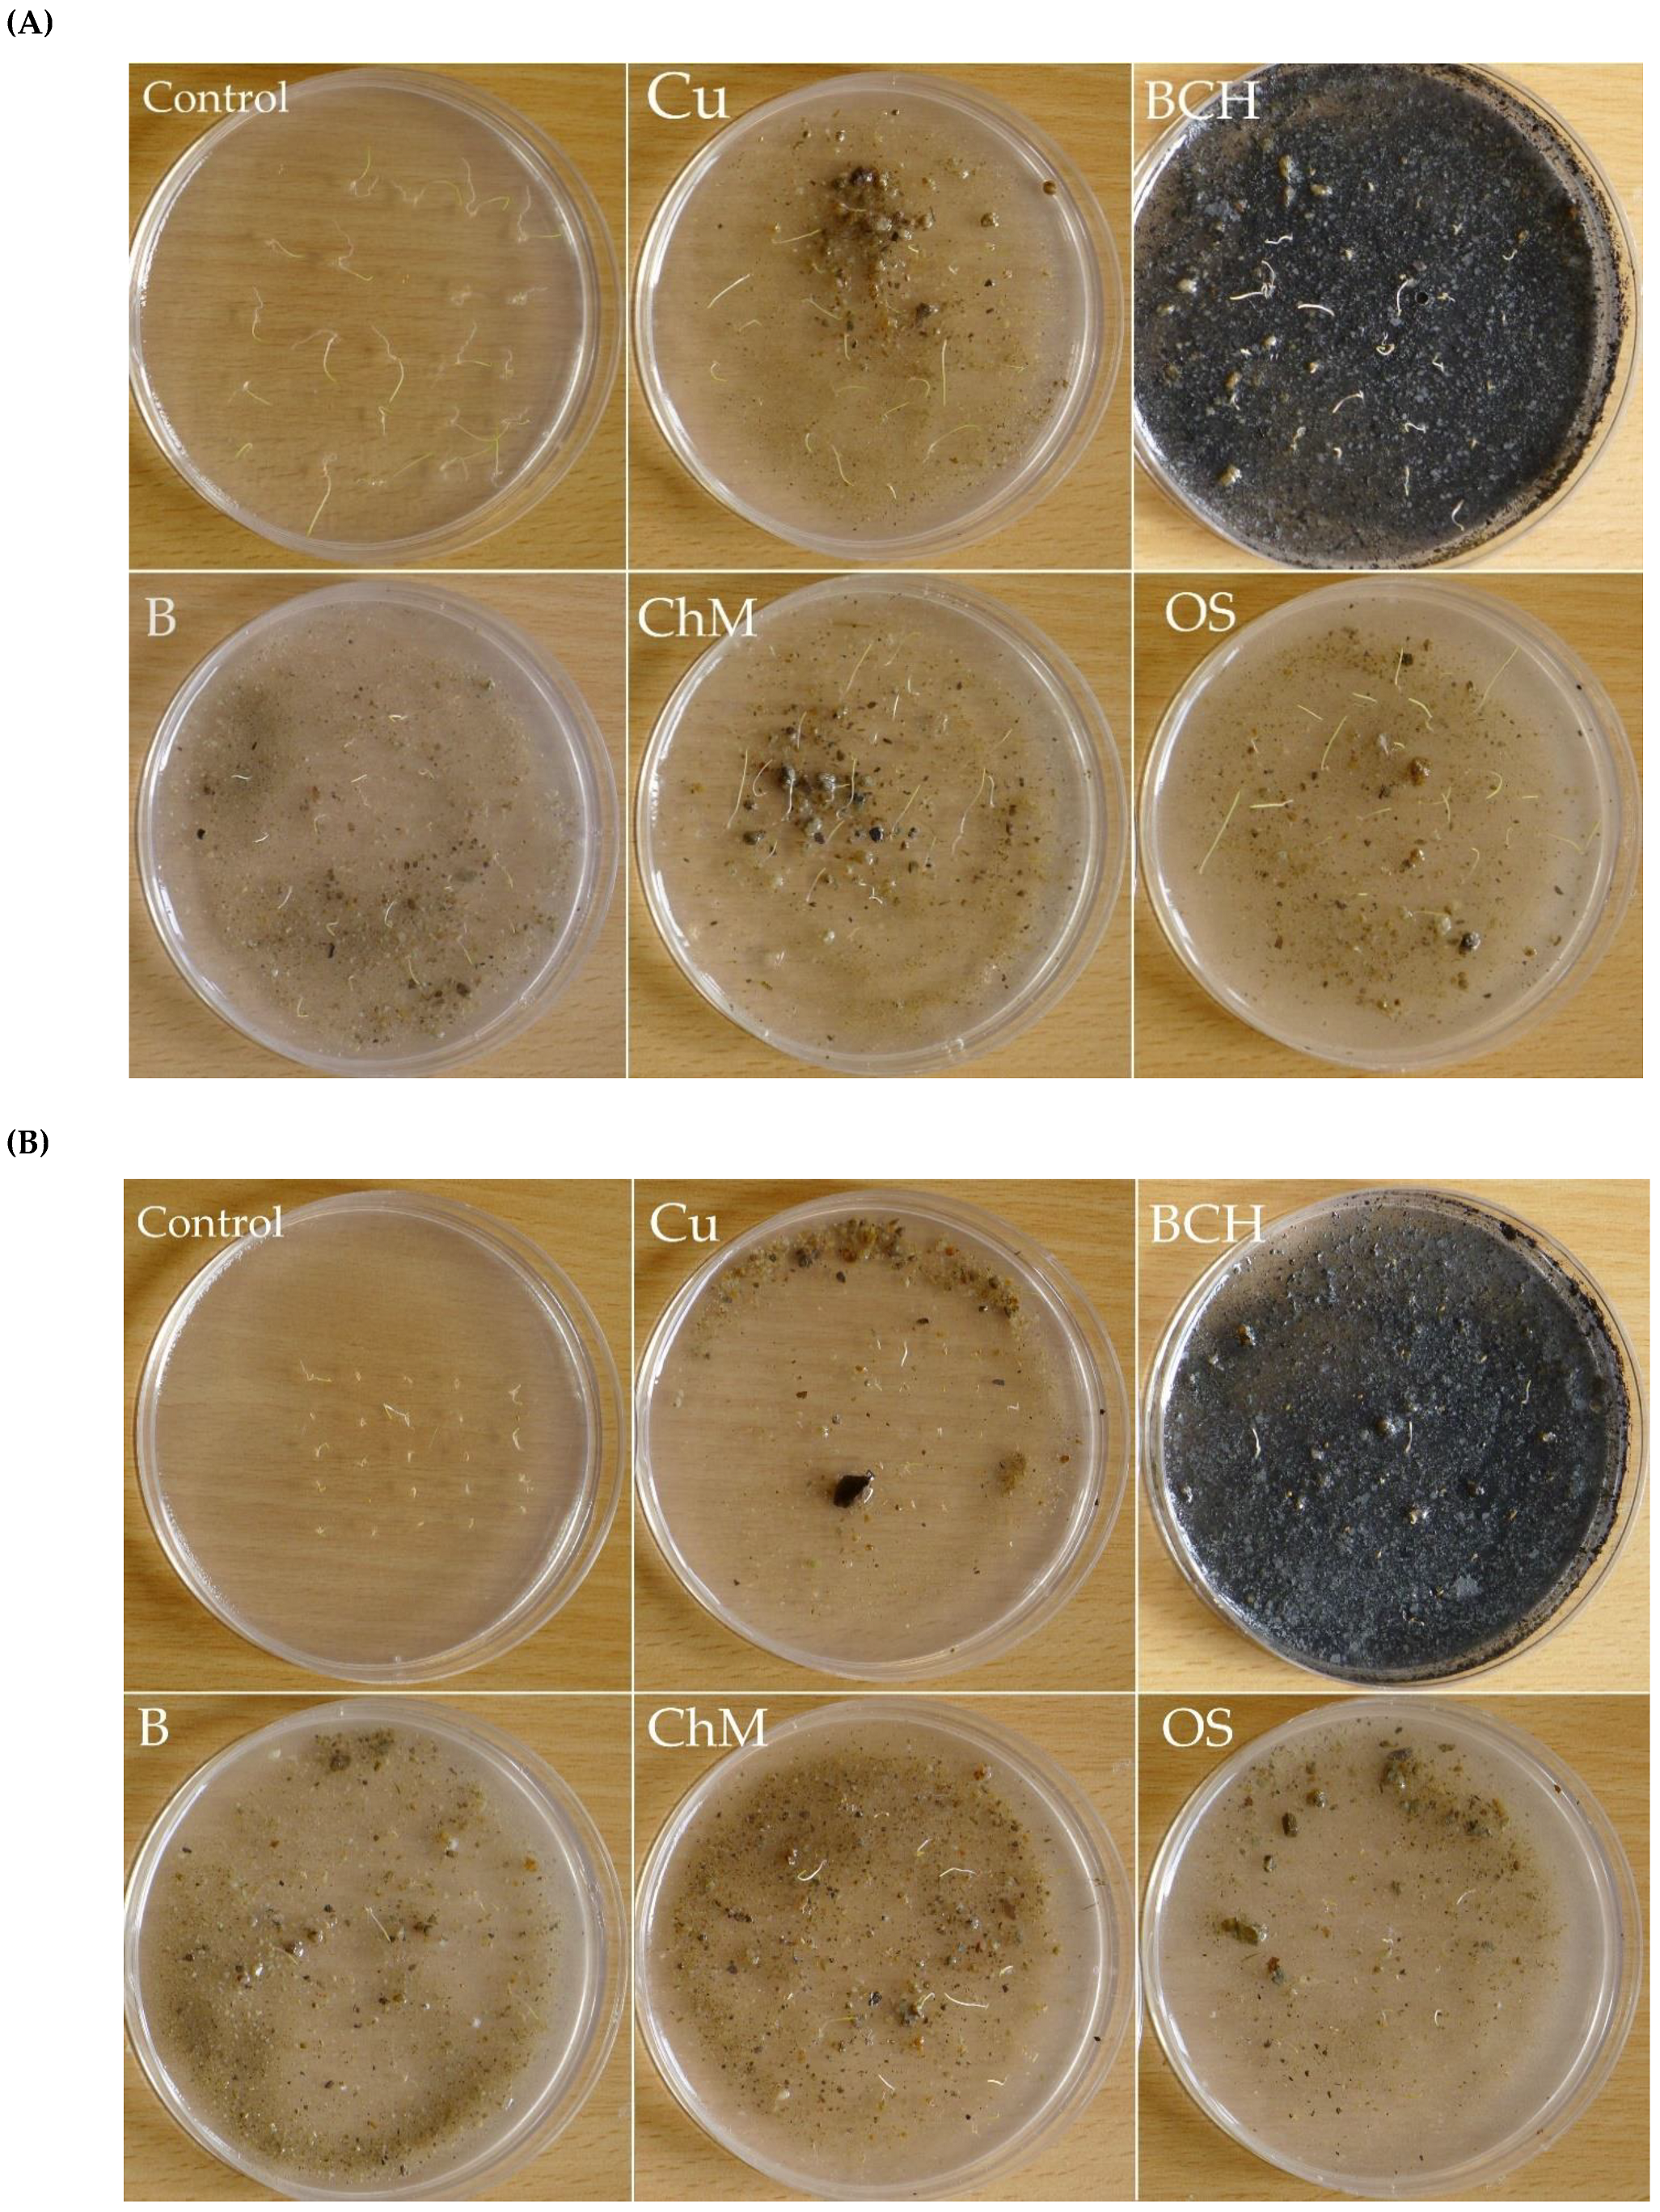
Molecules 26 05449 g003a

Effect of Sorbent Additives to Copper-Contaminated Soils on Seed Germination and Early Growth of Grass Seedlings
Abstract
1. Introduction
2. Results
2.1. Germination Capacity
2.2. Biometric Analysis
2.3. Fresh and Dry Masses and Total Water Content
2.4. Electrolyte Leakage
3. Discussion
4. Materials and Methods
4.1. Study Area
4.2. Soil Modification
4.3. Short Characteristics of Sorbents
4.4. Seed Material with Short Botanical Description of Species
4.5. Sandwich Methods
4.6. Seeds Preparation and Germination Conditions
4.7. Germination Parameters
n3 and n7 = number of germinated seeds on time T3 and T7, T3 and T7 = 3 and 7 days after germination.
C is the control germination speed and T is the treatment germination speed.
4.8. Biometric Analysis
LE—seedling length (cm) treated with the soil type, LC—seedling length (cm) treated with the distilled water (control group).
4.9. Fresh and Dry Masses and Total Water Content
DM—dry mass, FM—fresh mass.
4.10. Electrolyte Leakage
EL—electrolyte leakage, E1—EL live seedling, E2—EL dead seedling.
4.11. Statistical Analysis
5. Conclusions
Author Contributions
Funding
Institutional Review Board Statement
Informed Consent Statement
Data Availability Statement
Acknowledgments
Conflicts of Interest
Sample Availability
References
- Kabata-Pendias, A. Trace Elements in Soils and Plants, 4th ed.; CRC Press: Boca Raton, FL, USA, 2011; p. 548. [Google Scholar]
- Tchounwou, B.P.; Yedjou, G.C.; Patlolla, K.A.; Sutton, J.D. Heavy metals toxicity and the environment. Mol. Clin. Environ. Toxicol., Exp. Suppl. 2012, 101, 133–164. [Google Scholar] [CrossRef]
- Vareda, P.J.; Valente, J.M.A.; Durães, L. Heavy metals in Iberian soils: Removal by current adsorbents/ amendments and prospective for aerogels. Adv. Colloid Interface Sci. 2016, 237, 28–42. [Google Scholar] [CrossRef]
- Li, Y.; Padoan, E.; Ajmone-Marsan, F. Soil particle size fraction and potentially toxic elements bioaccessibility: A review. Ecotoxicol. Environ. Saf. 2021, 209, 111806:1–111806:9. [Google Scholar] [CrossRef] [PubMed]
- Järup, L. Hazards of heavy metal contamination. Br. Med Bull. 2003, 68, 167–182. [Google Scholar] [CrossRef]
- Turisová, I.; Sabo, P.; Štrba, T.; Koróny, S.; Andráš, P.; Širka, P. Analyses of floristic composition of the abandoned Cu-dump field Piesky (Staré Hory Mountains, Slovakia). Web. Ecol. 2016, 16, 97–111. [Google Scholar] [CrossRef]
- Lebrun, M.; Miard, F.; Nandillon, R.; Léger, J.-C.; Hattab-Hambli, N.; Scippa, S.G.; Bourgerie, S.; Morabito, D. Assisted phytostabilization of a multicontaminated mine technosol using biochar amendment: Early stage evaluation of biochar feedstock and particle size effects on As and Pb accumulation of two Salicaceae species (Salix viminalis and Populus euramericana). Chemosphere 2018, 194, 316–326. [Google Scholar] [CrossRef] [PubMed]
- Houben, D.; Evrard, L.; Sonnet, P. Beneficial effects of biochar application to contaminated soils on the bioavailability of Cd, Pb and Zn and the biomass production of rapeseed (Brassica napus L.). Biomass Bioener. 2013, 57, 196–204. [Google Scholar] [CrossRef]
- Khalid, S.; Shahid, M.; Niazi, K.N.; Murtaza, B.; Bibi, I.; Dumat, C. A comparison of technologies for remediation of heavy metal contaminated soils. J. Geochem. Explor. 2017, 187, 247–268. [Google Scholar] [CrossRef]
- Abumaizar, R.J.; Smith, E.H. Heavy metal contaminants removal by soil washing. J. Hazard. Mater. 1999, 70, 71–86. [Google Scholar] [CrossRef]
- Sun, W.; Ji, B.; Khoso, A.S.; Tang, H.; Liu, R.; Wang, L.; Hu, Y. An extensive review on restoration technologies for mining tailings. Environ. Sci. Poll. Res. 2018, 25, 33911–33925. [Google Scholar] [CrossRef]
- Rizwan, S.M.; Imtiaz, M.; Zhu, J.; Yousaf, B.; Hussain, M.; Ali, L.; Ditta, A.; Ihsan, Z.M.; Huang, G.; Ashraf, M.; et al. Immobilization of Pb and Cu by organic and inorganic amendments in contaminated soil. Geoderma 2021, 385, 114803:1–114803:12. [Google Scholar] [CrossRef]
- Deng, S. Sorbent technology. In Encyclopedia of Chemical Processing, 1st ed.; Lee, S., Ed.; CRC Press: Boca Raton, FL, USA, 2006; pp. 2825–2845. [Google Scholar]
- Gong, Y.; Zhao, D.; Wang, Q. An overview of field-scale studies on remediation of soil contaminated with heavy metals and metalloids: Technical progress over the last decade. Water Res. 2018, 147, 440–460. [Google Scholar] [CrossRef] [PubMed]
- Ling, W.; Shen, Q.; Gao, Y.; Gu, X.; Yang, Z. Use of bentonite to control the release of copper from contaminated soils. Aust. J. Soil Res. 2007, 455, 618–623. [Google Scholar] [CrossRef]
- Haydn, M.H. Bentonite applications. Dev. Clay Sci. 2006, 2, 111–130. [Google Scholar] [CrossRef]
- Hamidpour, M.; Kalbasi, M.; Afyuni, M.; Shariatmadari, H.; Holm, P.E.; Hansen, G.C.B. Sorption hysteresis of Cd(II) and Pb(II) on natural zeolite and bentonite. J. Hazard Mater. 2010, 181, 686–691. [Google Scholar] [CrossRef]
- Kumararaja, P.; Manjaiah, K.M.; Datta, C.S.; Shabeer, A.T.P. Potential of bentonite clay for heavy metal immobilization of soil. Clay Res. 2014, 33, 83–96. [Google Scholar]
- Sun, Y.; Li, Y.; Xu, Y.; Liang, X.; Wang, L. In situ stabilization remediation of cadmium (Cd) and lead (Pb)co-contaminated paddy soil using bentonite. Appl. Clay Sci. 2015, 105–106, 200–206. [Google Scholar] [CrossRef]
- Wahab, N.; Saeed, M.; Ibrahim, M.; Munir, A.; Saleem, M.; Zahra, M.; Waseem, A. Synthesis, characterization, and applications of silk/bentonite clay composite for heavy metal removal from aqueous solution. Front. Chem. 2019, 7, 654. [Google Scholar] [CrossRef]
- Akpomie, K.G.; Dawodu, F.A. Potential of a low-cost bentonite for heavy metal abstraction from binary component system. Beni-Suef Univ. J. Basic Appl. Sci. 2015, 4, 1–13. [Google Scholar] [CrossRef]
- Mi, J.; Gregorich, E.G.; Xu, S.; McLaughlin, N.B.; Ma, B.; Liu, J. Effect of bentonite amendment on soil hydraulic parameters and millet crop performance in a semi-arid region. J. Field Crop. Res. 2017, 212, 107–114. [Google Scholar] [CrossRef]
- De Castro, M.L.F.A.; Abad, M.L.B.; Sumalinog, D.A.G.; Abarca, R.R.M.; Paoprasert, P.; de Luna, M.D.G. Adsorption of methylene blue dye and Cu(II) ions on EDTA-modified bentonite: Isotherm, kinetic and thermodynamic studies. J. Sustain. Environ. Res. 2018, 28, 197–205. [Google Scholar] [CrossRef]
- Lehmann, J.; Joseph, S. Biochar for environmental management an introduction. In Biochar for Environmental Management Science and Technology, 1st ed.; Lehmann, J., Joseph, S., Eds.; Earthscan: London, UK, 2009; pp. 1–9. [Google Scholar]
- Ahmad, M.; Rajapaksha, A.U.; Lim, E.J.; Zhang, M.; Bolan, N.; Mohan, D.; Vithanage, M.; Lee, S.S.; Ok, S.Y. Biochar as a sorbent for contaminant management in soil and water: A review. Chemosphere 2014, 99, 19–33. [Google Scholar] [CrossRef]
- Uchimiya, M.; Lima, I.M.; Thomas Klasson, K.; Chang, S.; Wartelle, L.H.; Rodgers, J.E. Immobilization of heavy metal ions (CuII, CdII, NiII, and PbII) by broiler litter-derived biochars in water and soil. J. Agr. Food Chem. 2010, 58, 5538–5544. [Google Scholar] [CrossRef]
- Lu, H.; Li, Z.; Fu, S.; Méndez, A.; Gascó, G.; Paz-Ferreiro, J. Combining phytoextraction and biochar addition improves soil biochemical properties in a soil contaminated with Cd. Chemosphere 2015, 119, 209–216. [Google Scholar] [CrossRef]
- Lee, S.; Shah, H.; Awad, Y.; Kumar, S.; Ok, Y.S. Synergy effects of biochar and polyacrylamide on plants growth and soil erosion control. Environ. Earth Sci. 2015, 74, 2463–2473. [Google Scholar] [CrossRef]
- Laird, D.A.; Brown, R.C.; Amonette, J.E.; Lehmann, J. Review of the pyrolysis platform for coproducing bio-oil and biochar. Biofpr Biofuels Bioprod. Biorefining 2009, 3, 547–562. [Google Scholar] [CrossRef]
- Major, J.; Lehmann, J.; Rondon, M.; Goodale, C. Fate of soil-applied black carbon: Downward migration, leaching and soil respiration. Glob. Chang. Biol. 2010, 16, 1366–1379. [Google Scholar] [CrossRef]
- Wang, D.; Jiang, P.; Zhang, H.; Yuan, W. Biochar production and applications in agro and forestry systems: A review. Sci. Total Environ. 2020, 723, 137775. [Google Scholar] [CrossRef]
- Lucchini, P.; Quilliam, R.S.; DeLuca, T.H.; Vameruli, T.; Jones, D.L. Does biochar application alter heavy metal dynamics in agricultural soil? Agric. Ecosyst. Environ. 2014, 184, 149–157. [Google Scholar] [CrossRef]
- Rajapaksha, A.; Ahmad, M.; Vithanage, M. The role of biochar, natural iron oxides, and nanomaterials as soil amendments for immobilizing metals in shooting range soil. Environ. Geochem. Health 2015, 37, 931–942. [Google Scholar] [CrossRef] [PubMed]
- Park, J.H.; Choppala, G.K.; Bolan, N.S.; Chung, J.W.; Chuasavathi, T. Biochar reduces the bioavailability and phytotoxicity of heavy metals. Plant Soil 2011, 348, 439–451. [Google Scholar] [CrossRef]
- Bian, R.; Joseph, S.; Cui, L.; Pan, G.; Li, L.; Liu, X.; Zhang, A.; Rutlidge, H.; Wong, S.; Chia, C.; et al. A three-year experiment confirms continuous immobilization of cadmium and lead in contaminated paddy field with biochar amendment. J. Hazard. Mater. 2014, 272, 121–128. [Google Scholar] [CrossRef]
- Puga, P.A.; Abreu, C.A.; Melo, L.C.A.; Beesley, L. Biochar application to a contaminated soil reduces the availability andplant uptake of zinc, lead and cadmium. J. Environ. Manag. 2015, 159, 86–93. [Google Scholar] [CrossRef]
- Nie, C.R.; Yang, X.; Niazi, N.K.; Xu, X.Y.; Wen, Y.H.; Rinklebe, J.; Ok, Y.S.; Xu, S.; Wang, H.L. Impact of sugarcane bagasse-derived biochar on heavy metal availability and microbial activity: A field study. Chemosphere 2018, 200, 274–281. [Google Scholar] [CrossRef]
- Vijayaraghavan, K.; Raja, D.F. Experimental characterisation and evaluation of perlite as a sorbent for heavy metal ions in single and quaternary solutions. J. Water Process Eng. 2014, 4, 179–184. [Google Scholar] [CrossRef]
- Barakat, M.A.; Ismail, S.M.; Ehsan, M. Immobilization of Ni and Zn in soil by cow and chicken manure. Int. J. Waste Res. 2016, 6, 1000228:1–1000228:7. [Google Scholar] [CrossRef]
- Huang, Q.; Wan, Y.; Luo, Z.; Qiao, Y.; Su, D.; Li, H. The effects of chicken manure on the immobilization and bioavailability of cadmium in the soil-rice system. Arch. Agr. Soil Sci. 2019, 66, 1753–1764. [Google Scholar] [CrossRef]
- Huang, G.; Su, X.; Rizwan, M.S.; Zhu, Y.; Hu, H. Chemical immobilization of Pb, Cu, and Cd by phosphate materials and calcium carbonate in contaminated soils. Environ. Sci. Poll. Res. Int. 2016, 23, 16845–16856. [Google Scholar] [CrossRef] [PubMed]
- He, G.; Zhang, Z.; Wu, X.; Cui, M.; Zhang, J.; Huang, X. Adsorption of heavy metals on soil collected from lixisol of typical karst areas in the presence of CaCO3 and soil clay and their competition behavior. Sustainability 2020, 12, 7315. [Google Scholar] [CrossRef]
- Damian, G.; Andráš, P.; Damian, F.; Turisová, I.; Iepure, G. The role of organo-zeolitic material in supporting phytoremediation of a copper mining waste dump. Int. J. Phytoremediat. 2018, 20, 1307–1316. [Google Scholar] [CrossRef] [PubMed]
- Damian, F.; Jelea, S.G.; Lăcătuşu, R.; Mihali, C. The treatment of soil polluted with heavy metals using the Sinapis alba l. and organo zeolitic amendment. Carpathian J. Earth Environ. Sci. 2019, 14, 409–422. [Google Scholar] [CrossRef]
- Jakkula, V.S.; Wani, S.P. Zeolites: Zeolites: Potential soil amendments for improving nutrient and water use efficiency and agriculture productivity. Sci. Revs. Chem. Commun. 2018, 8, 119. [Google Scholar]
- Zeng, F.; Ali, S.; Zhang, H.; Ouyang, Y.; Qiu, B.; Wu, F.; Zang, G. The influence of pH and organic matter content in paddy soil on heavy metal availability and their uptake by rice plants. Environ. Poll. 2011, 159, 84–91. [Google Scholar] [CrossRef]
- Castaldi, P.; Alberti, G.; Merella, R.; Melis, P. Study of the organic matter evolution during municipal solid waste composting aimed at identifying suitable parameters for the evaluation of compost maturity. Waste Manag. 2005, 25, 209–213. [Google Scholar] [CrossRef] [PubMed]
- Prost, R.; Yaron, B. Use of modified clays for controlling soil environmental quality. Soil Sci. 2001, 166, 880–895. [Google Scholar] [CrossRef]
- Usman, A.; Kuzyakov, Y.; Stahr, K. Effect of clay minerals on immobilization of heavy metals and microbial activity in a sewage sludge-contaminated soil (8pp). J. Soils Sediments 2005, 5, 245–252. [Google Scholar] [CrossRef]
- Herath, I.; Kumarathilaka, P.; Navaratne, A.; Rajakaruna, N.; Vithanage, M. Immobilization and phytotoxicity reduction of heavy metals in serpentine soil using biochar. J. Soils Sediments 2015, 15, 126–138. [Google Scholar] [CrossRef]
- Herath, I.; Iqbal, M.C.M.; Al-Wabel, M.I.; Abduljabbar, A.; Ahmad, M.; Usman, A.R.A.; Ok, Y.S.; Vithanage, M. Bioenergy-derived waste biochar for reducing mobility, bioavailability, and phytotoxicity of chromium in anthropized tannery soil. J. Soils Sediments 2017, 17, 731–740. [Google Scholar] [CrossRef]
- Turisová, I.; Kviatková, T.; Możdżeń, K.; Barabasz-Krasny, B. Effects of natural sorbents on the germination and early growth of grasses on soils contaminated by potentially toxic elements. Plants 2020, 9, 1591. [Google Scholar] [CrossRef]
- Guala, S.D.; Vega, F.A.; Covelo, E.F. The dynamics of heavy metals in plant-soil interactions. Ecol. Model. 2010, 221, 1148–1152. [Google Scholar] [CrossRef]
- Nedelkoska, T.V.; Doran, P.M. Characteristics of heavy metal uptake by plant species with potential for phytoremediation and phytomining. Miner. Eng. 2000, 13, 549–561. [Google Scholar] [CrossRef]
- Bewley, J.D. Seed germination and dormancy. Plant Cell 1997, 9, 1055. [Google Scholar] [CrossRef]
- Seneviratne, M.; Rajakaruna, N.; Rizwan, M.; Madawala, H.M.S.P.; Ok, Y.S.; Vithanage, M. Heavy metal-induced oxidative stress on seed germination and seedling development: A critical review. Environ. Geochem. Health 2019, 41, 1813–1831. [Google Scholar] [CrossRef] [PubMed]
- Singh, D.; Nath, K.; Sharma, Y.K. Response of wheat seed germination and seedling growth under copper stress. J. Environ. Biol. 2007, 28, 409–414. [Google Scholar] [PubMed]
- Sfaxi-Bousbih, A.; Chaoui, A.; El Ferjani, E. Copper affects the cotyledonary carbohydrate status during the germination of bean seed. Biol. Trace Elem. Res. 2010, 137, 110–116. [Google Scholar] [CrossRef] [PubMed]
- Pena, L.B.; Azpilicueta, C.E.; Gallego, S.M. Sunflower cotyledons cope with copper stress by inducing catalase subunits less sensitive to oxidation. J. Trace Elem. Med. Biol. 2011, 25, 125–129. [Google Scholar] [CrossRef]
- Iqbal, M.Z.; Habiba, U.; Nayab, S.; Shafiq, M. Effects of copper on seed germination and seedling growth performance of Lens culinaris Medik. J. Plant Develop. 2018, 25, 85–90. [Google Scholar] [CrossRef]
- Karmous, I.; Jaouani, K.; El Ferjani, E.; Chaoui, A. Responses of proteolytic enzymes in embryonic axes of germinating bean seeds under copper stress. Biol. Trace Elem. Res. 2014, 160, 108–115. [Google Scholar] [CrossRef]
- Zhang, H.; Lian, C.; Shen, Z. Proteomic identification of small, copper-responsive proteins in germinating embryos of Oryza sativa. Ann. Bot. 2009, 103, 923–930. [Google Scholar] [CrossRef]
- Paganini, W.S.; Souza, A.; Bocchiglieri, M.M. Assessment of the behavior of heavy metals in the sewage treatment by disposal in soil. Eng. Sanit Ambient 2004, 9, 225–239. [Google Scholar] [CrossRef]
- Yan, D.; Duermeyer, L.; Leoveanu, C.; Nambara, E. The functions of the endosperm during seed germination. Plant Cell Physiol. 2014, 55, 1521–1533. [Google Scholar] [CrossRef]
- Adrees, M.; Ali, S.; Rizwan, M.; Ibrahim, M.; Abbas, F.; Farid, M.; Rehman, M.-U.-Z.; Irshad, M.K.; Bharwana, S.A. The effect of excess copper on growth and physiology of important food crops: A review. Environ. Sci. Poll. Res. 2015, 22, 8148–8162. [Google Scholar] [CrossRef] [PubMed]
- Wierzbicka, M.; Obidzińska, J. The effect of lead on seed imbibition and germination in different plant species. Plant Sci. 1998, 137, 155–171. [Google Scholar] [CrossRef]
- Conway, J.R.; Keller, A.A. Gravity-driven transport of three engineered nanomaterials in un-saturated soils and their effects on soil pH and nutrient release. Water Res. 2016, 98, 250–260. [Google Scholar] [CrossRef] [PubMed]
- Meier, S.; Curaqueo, G.; Khan, N.; Bolan, N.; Cea, M.; Eugenia, G.M.; Cornejo, P.; Ok, Y.S.; Borie, F.; Bolan, N.; et al. Chicken-manure-derived biochar reduced bioavailability of copper in a contaminated soil. J. Soils Sediments 2017, 17, 741–750. [Google Scholar] [CrossRef]
- Finch-Savage, W.E.; Bassel, G.W. Seed vigour and crop establishment: Extending performance beyond adaptation. J. Exp. Bot. 2016, 67, 567–591. [Google Scholar] [CrossRef]
- Turisová, I.; Kviatková, T. Effect of sorbents added to contaminated soils on vitality and growth of grass seeds. In Proceeding of the Geochémia 2019, Častá—Papiernička, 3–4 December 2019; Jurkovič, Ľ., Slaninka, I., Kordík, J., Eds.; State Geological Institute of Dionyz Stur: Bratislava, Slovakia, 2019; pp. 163–164. [Google Scholar]
- Winseminus, P. Council Directive, no. 86/278/EEC of 12 June 1986 on the protection of the environment, and in particular of the soil, when sewage sludge is used in agriculture. OJEU 1986, 181, 10. [Google Scholar]
- Michňová, J.; Ozdín, D. Primárna hydrotermálna mineralizácia na lokalite Polkanová. Miner. Slovaca 2010, 42, 69–78. [Google Scholar]
- Koděra, M.; Andrusovová-Vlčeková, G.; Belešová, O.; Briatková, D.; Dávidová, Š.; Fejdiová, Š.; Hurai, V.; Chovan, M.; Nelišerová, E.; Ženiš, P. Topografická mineralógia Slovenska 3, Sed—Ž, 1st ed.; Veda: Bratislava, Slovakia, 1990; pp. 1105–1590. ISBN 80-224-0102-1. [Google Scholar]
- Jeleň, S.; Galvánek, J.; Andráš, P.; Bendík, A.; Beláček, B.; Bozalková, I.; Gaál, Ľ.; Gajdoš, A.; Háber, M.; Konečný, V.; et al. Náučno-Poznávací Sprievodca po Geologických a Geografických Lokalitách Stredného Slovenska; Geologický ústav SAV: Banská Bystrica, Slovakia, 2009; p. 320. ISBN 978-80-970413-4-2. [Google Scholar]
- Mazúrek, J. Ťažobný prírodno-technický systém v banskej oblasti Špania Dolina—Staré Hory. Stredné Slovensko 8. Prírodné Vedy 1989, 69, 23–68. [Google Scholar]
- Montanarella, L.; Lugato, E. The application of biochar in the EU: Challenges and opportunities. Agronomy 2013, 3, 462–473. [Google Scholar] [CrossRef]
- Vereš, J.; Koloničný, J.; Ochodek, T. Biochar status under international law and regulatory issues for the practical application. Chem. Eng. Trans. 2014, 37, 799–804. [Google Scholar] [CrossRef]
- Tang, J.; Zhy, W.; Kookana, R.; Katayama, A. Characteristics of biochar and its application in remediation of contaminated soil. J. Bioresour. Bioeng. 2013, 116, 653–659. [Google Scholar] [CrossRef]
- Mohan, D.; Sarswat, A.; Ok, S.Y.; Pittman, C.U., Jr. Organic and inorganic contaminants removal from water with biochar, a renewable, low cost and sustainable adsorbent—A critical review. Bioresour. Technol. 2014, 160, 191–202. [Google Scholar] [CrossRef] [PubMed]
- Kviatková, T.; Alberty, R.; Barabasz-Krasny, B.; Możdżeń, K.; Andráš, P.; Turisová, I. The contribution of natural sorbents to the improvement of the properties of contaminated technosols evaluated by the development of vegetation cover. Carpathian J. Earth Environ. Sci. 2021, 16, 305–313. [Google Scholar] [CrossRef]
- Kozáč, J. Nerastné suroviny ako sorbenty katiónov ťažkých a toxických kovov a základná zložka čistiacich prostriedkov. Miner. Slovaca Geovestník 1996, 28, 5–7. [Google Scholar]
- Wyszomirski, P.; Lewicka, E. Bentonity jako uniwersalny surowiec wielu dziedzin przemysłu. Gospod. Surowcami Miner. 2005, 21, 5–19. [Google Scholar]
- Adeli, A.; Shankle, M.W.; Tewolde, H.; Sistani, K.R.; Rrowe, D.E. Nutrient dynamics from broiler litter applied to no-till cotton in an upland soil. Agron. J. 2008, 100, 564–570. [Google Scholar] [CrossRef]
- Kadian, N.; Gupta, A.; Satya, S.; Mehta, R.K.; Malik, A. Biodegradation of herbicide (atrazine) in contaminated soil using various bioprocessed materials. Bioresour. Technol. 2008, 99, 4642–4647. [Google Scholar] [CrossRef]
- Filipek, J. Project of classification of meadow and pasture plants on the basis of the number of utility value (Projekt klasyfikacji roślin łąkowych i pastwiskowych na podstawie liczby wartości użytkowej). Postępy Nauk Rol. 1973, 4, 59–68. [Google Scholar]
- Tlustoš, P.; Száková, K.; Kořinek, K.; Pavlíková, D.; Hanač, A.; Balík, J. The effect of liming on cadmium, lead, and zinc uptakereduction by spring wheat grown in contaminated soil. Plant Soil Environ. 2006, 52, 16–24. [Google Scholar] [CrossRef]
- Zhong, Q.Y.; Zeng, M.; Liao, B.H.; Li, J.F.; Kong, X.Y. Effects of CaCO3 addition on uptake of heavy metals and arsenic in paddy fields. Acta Ecol. Sin. 2015, 35, 1242–1248. [Google Scholar]
- Szafer, W.; Kulczyński, S.; Pawłowski, B. Rośliny Polskie. Opisy i Klucze do Oznaczania Wszystkich Gatunków Roślin Naczyniowych Rosnących w Polsce bądź Dziko, bądź też Zdziczałych lub Częściej Hodowanych; Wydawnictwo Naukowe PWN: Warsaw, Poland, 1988; ISBN 8301052872. [Google Scholar]
- Fujii, Y.; Shibuya, T.; Nakatani, K.; Itani, T.; Hiradate, S.; Parvez, M.M. Assessment method for allelopathic effect from leaf litter leachates. Weed Biol. Manag. 2004, 4, 19–23. [Google Scholar] [CrossRef]
- Islam, A.K.M.A.; Anuar, N.; Yaakob, Z. Effect of genotypes and pre-sowing treatments on seed germination behavior of Jatropha. Asian J. Plant Sci. 2009, 8, 433–439. [Google Scholar] [CrossRef]
- AOSA (Association of Official Seed Analysis). Seed vigour testing. In Handbook on Seed Testing; Anmol Publications Pvt. Ltd.: New Delhi, India, 1983. [Google Scholar]
- Ali, H.H.; Tanveer, A.; Nadeem, M.A.; Javaid, M.M.; Kashif, M.S.; Andchadhar, A.R. Allelopathic effects of Rhynchosia capitata on germination and seedling growth of mung bean. Planta Daninha 2013, 31, 501–509. [Google Scholar] [CrossRef]
- Chiapusio, G.; Sanchez, A.M.; Reigosa, M.J.; Gonzalez, L.; Pellissier, F. Do germination indices adequately reflect allelochemical effects on the germination process? J. Chem. Ecol. 1997, 23, 2445–2453. [Google Scholar] [CrossRef]
- Gao, X.; Li, M.; Gao, Z.; Li, C.; Sun, Z. Allelopathic effects of Hemistepta lyrata on the germination and growth of wheat, sorghum, cucumber, rape, and radish seeds. Weed Biol. Manag. 2009, 9, 243–249. [Google Scholar] [CrossRef]
- Mominul Islam, A.K.M.; Kato-Noguchi, H. Allelopathic potentiality of medicinal plant Leucas aspera. Int. J. Agric. Sustain. 2012, 4, 1–7. [Google Scholar]
- Lipniak, K.; Kliszcz, A. Allelopathic effect of goosefoot on germination and early stage growth of triticale and radish. AUPC Studia Nat. 2020, 5, 110–128. [Google Scholar] [CrossRef]
- Szafraniec, R.; Możdżeń, K.; Barabasz-Krasny, B.; Zandi, P.; Wang, Y. Influence of volatile peppermint (Mentha ×piperita L.) compounds on germination and seedling of radish (Raphanus sativus L. var. radicula Pers.) growth. Not. Bot. Horti Agrobot. Cluj Napoca 2019, 47, 1277–1284. [Google Scholar] [CrossRef]

| Soil Type | GR3 (%) | GR7 (%) | SE (%) | GI (a.u.) | ||||||||||||
|---|---|---|---|---|---|---|---|---|---|---|---|---|---|---|---|---|
| AC | AS | FR | PP | AC | AS | FR | PP | AC | AS | FR | PP | AC | AS | FR | PP | |
| Control | 81.6 a ± 5.37 | 11.2 a ± 1.16 | 81.6 a ± 6.07 | 33.6 b ± 6.78 | 88.0 a ± 5.66 | 40.0 a ± 5.98 | 82.4 a ± 6.69 | 89.6 a ± 2.05 | 92.8 a ± 4.07 | 52.9 a ± 6.31 | 99.1 a ± 2.03 | 38.2 a ± 0.58 | 9.9 a ± 0.62 | 2.0 a ± 1.31 | 9.7 a ± 0.74 | 6.0 b ± 0.31 |
| Cu | 73.6 ab ± 7.80 | 7.2 ab ± 1.67 | 34.4 c ± 7.48 | 42.4 a ± 4.38 | 87.2 a ± 6.57 | 24.0 ab ± 6.02 | 84.0 a ± 6.34 | 92.8 a ± 2.42 | 84.5 ab ± 8.16 | 13.8 b ± 6.73 | 41.5 c ± 0.78 | 45.7 a ± 0.38 | 9.2 ab ± 0.79 | 1.8 a ± 0.88 | 5.9 b ± 0.27 | 6.8 a ± 0.16 |
| BCH | 12.0 c ± 8.94 | 0.0 d ± 0.00 | 33.6 bc ± 6.07 | 2.4 cd ± 6.78 | 84.8 a ± 8.67 | 28.0 ab ± 4.90 | 78.4 a ± 6.60 | 77.6 bc ± 2.72 | 13.4 c ± 9.39 | 0.0 e ± 0.00 | 43.4 bc ± 0.70 | 3.0 bc ± 0.44 | 4.0 c ± 1.05 | 1.0 a ± 0.17 | 5.6 bc ± 0.22 | 3.0 c ± 0.31 |
| B | 12.0 c ± 9.31 | 3.2 bc ± 1.94 | 44.0 b ± 6.46 | 0.8 cd ± 6.32 | 88.0 a ± 6.32 | 28.0 ab ± 4.88 | 80.8 a ± 6.20 | 68.0 cd ± 2.35 | 13.5 c ± 9.40 | 14.5 b ± 1.25 | 55.7 b ± 0.48 | 1.0 cd ± 0.35 | 4.1 c ± 1.02 | 1.3 a ± 0.32 | 6.6 b ± 0.44 | 2.5 c ± 0.23 |
| ChM | 5.6 cd ± 6.69 | 0.8 bc ± 1.85 | 20.8 d ± 7.48 | 0.0 d ± 0.00 | 88.0 a ± 6.52 | 32.8 ab ± 2.98 | 84.0 a ± 6.04 | 75.2 bd ± 2.00 | 6.4 cd ± 7.34 | 1.3 d ± 1.71 | 24.2 d ± 1.02 | 0.0 d ± 0.37 | 3.6 cd ± 0.81 | 1.2 a ± 0.57 | 4.7 c ± 0.27 | 2.7 c ± 0.37 |
| OS | 64.0 b ± 5.52 | 1.6 bc ± 1.45 | 39.2 b ± 4.60 | 0.8 cd ± 6.28 | 84.8 a ± 6.27 | 33.6 ab ± 3.36 | 88.0 a ± 6.40 | 85.6 ab ± 2.48 | 76.3 b ± 2.84 | 5.4 c ± 1.47 | 45.1 bc ± 0.86 | 1.1 cd ± 0.17 | 8.4 b ± 0.82 | 1.3 a ± 0.48 | 6.4 b ± 0.17 | 3.1 c ± 0.30 |
| Parameter | Species | Cu | Type of Sorbents | |||
|---|---|---|---|---|---|---|
| BCH | B | ChM | OS | |||
| Germination | ||||||
| RG | AC | |||||
| AS | ||||||
| FR | ||||||
| PP | ||||||
| SVI | AC | |||||
| AS | ||||||
| FR | ||||||
| PP | ||||||
| RI | AC | |||||
| AS | ||||||
| FR | ||||||
| PP | ||||||
| Growth of seedlings | ||||||
| Length Whole Seedling | AC | |||||
| AS | ||||||
| FR | ||||||
| PP | ||||||
| FM | AC | |||||
| AS | ||||||
| FR | ||||||
| PP | ||||||
| DM | AC | |||||
| AS | ||||||
| FR | ||||||
| PP | ||||||
| EL | AC | |||||
| AS | ||||||
| FR | ||||||
| PP | ||||||
| Abbreviation | Soil | BCH | B | ChM | OS |
|---|---|---|---|---|---|
| Full name | Cu-contaminated soil froma mining heap0.5 g | biochar | bentonite | chicken manure | organo-zeolitic substrate |
| Mixture proportions per 1 unit weight of soil (g) | 0.2 g—biochar | 0.1 g—bentonite | 0.01 g—chicken manure | 0.5 g—perlite0.3 g—CaCO30.1 g—chicken manure | |
| 0.8 g—soil | 0.9 g—soil | 0.99 g—soil | 0.91 g—soil |
Publisher’s Note: MDPI stays neutral with regard to jurisdictional claims in published maps and institutional affiliations. |
© 2021 by the authors. Licensee MDPI, Basel, Switzerland. This article is an open access article distributed under the terms and conditions of the Creative Commons Attribution (CC BY) license (https://creativecommons.org/licenses/by/4.0/).
Share and Cite
Możdżeń, K.; Barabasz-Krasny, B.; Kviatková, T.; Zandi, P.; Turisová, I. Effect of Sorbent Additives to Copper-Contaminated Soils on Seed Germination and Early Growth of Grass Seedlings. Molecules 2021, 26, 5449. https://doi.org/10.3390/molecules26185449
Możdżeń K, Barabasz-Krasny B, Kviatková T, Zandi P, Turisová I. Effect of Sorbent Additives to Copper-Contaminated Soils on Seed Germination and Early Growth of Grass Seedlings. Molecules. 2021; 26(18):5449. https://doi.org/10.3390/molecules26185449
Chicago/Turabian StyleMożdżeń, Katarzyna, Beata Barabasz-Krasny, Tatiana Kviatková, Peiman Zandi, and Ingrid Turisová. 2021. "Effect of Sorbent Additives to Copper-Contaminated Soils on Seed Germination and Early Growth of Grass Seedlings" Molecules 26, no. 18: 5449. https://doi.org/10.3390/molecules26185449
APA StyleMożdżeń, K., Barabasz-Krasny, B., Kviatková, T., Zandi, P., & Turisová, I. (2021). Effect of Sorbent Additives to Copper-Contaminated Soils on Seed Germination and Early Growth of Grass Seedlings. Molecules, 26(18), 5449. https://doi.org/10.3390/molecules26185449

